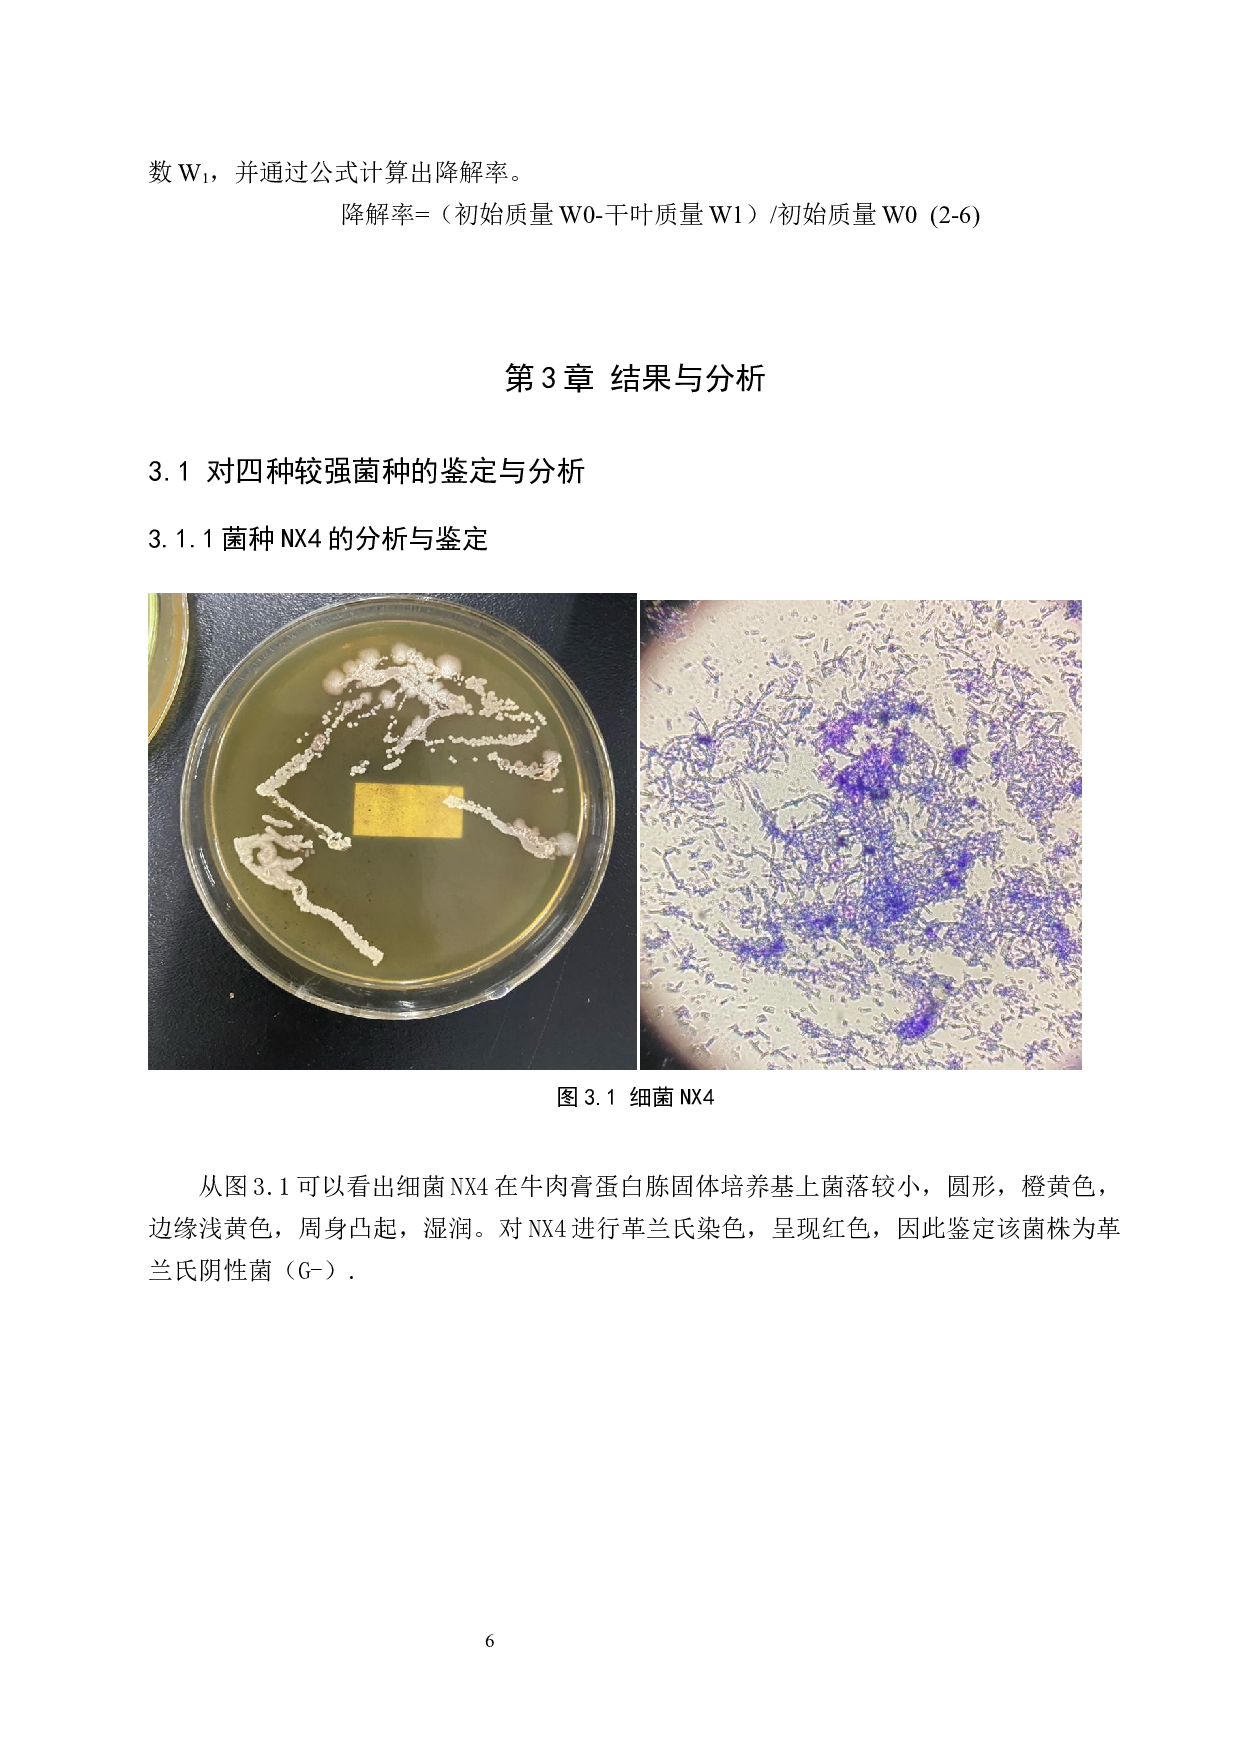
柳树落叶分解菌种初步鉴定及菌剂研制-7761字.docx 第9页
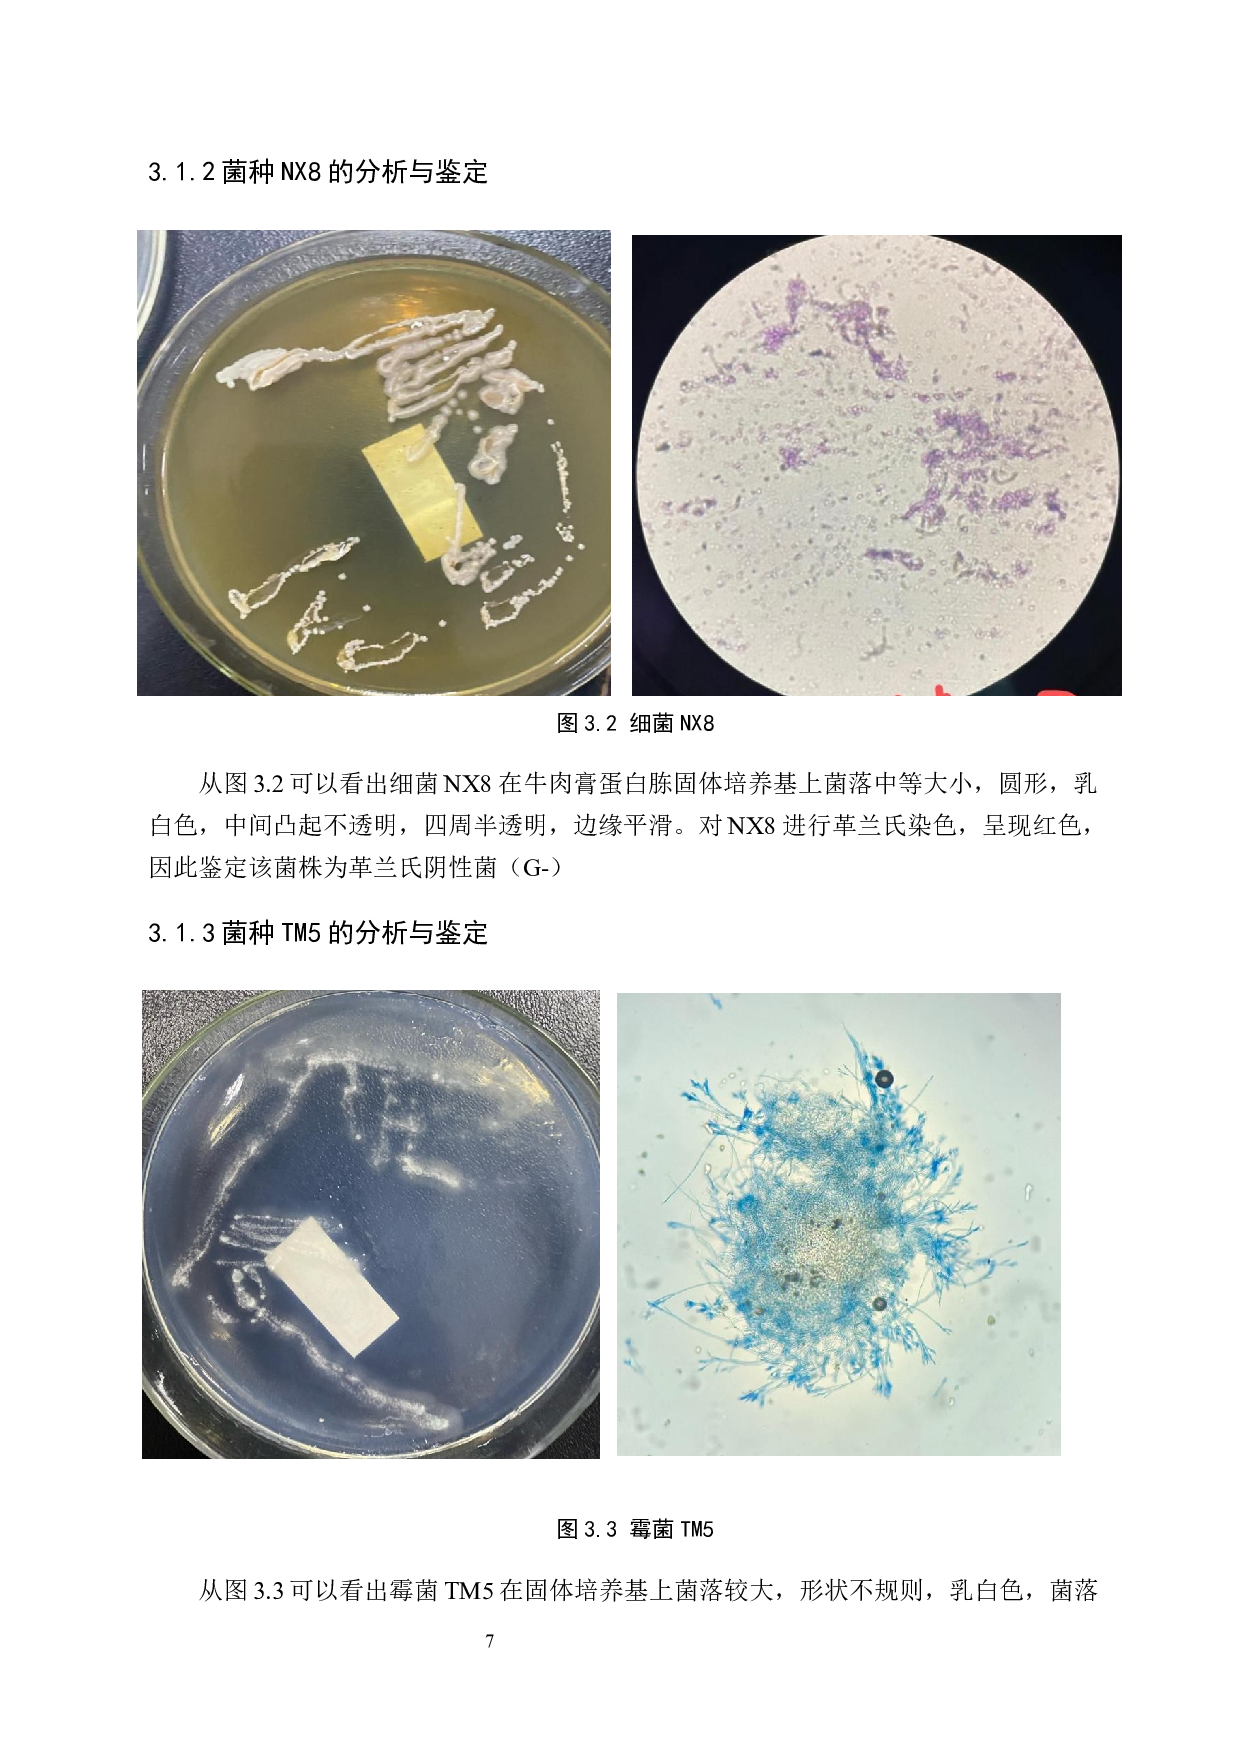
柳树落叶分解菌种初步鉴定及菌剂研制-7761字.docx 第10页

摘
要
柳树落叶尽快分解,养分还田迫在眉睫。据资料显示,复合菌系对凋落物的分解程度优于单一菌种,复合菌剂研究成为目前的热点。本实验
选取已经从柳树种植区域的土壤微生物中分离出的四种降解能力较强菌种为研究对象,先进行染色镜鉴通过观察比较分析得出四种土壤微生物分别是两种细菌、一种霉菌、一种酵母菌,并对其分别命名为
NX4
、
NX8
、
TM5
、
GJ3
。
再以柳树落叶的降解率为指标
,
通过单因素正交试验配置复合降解菌剂
。主要实验为
对四种菌株设置不同浓度进行实验,并以
降解率
的大小来判断同种微生物不同浓度的分解能
柳树落叶分解菌种初步鉴定及菌剂研制-7761字.docx